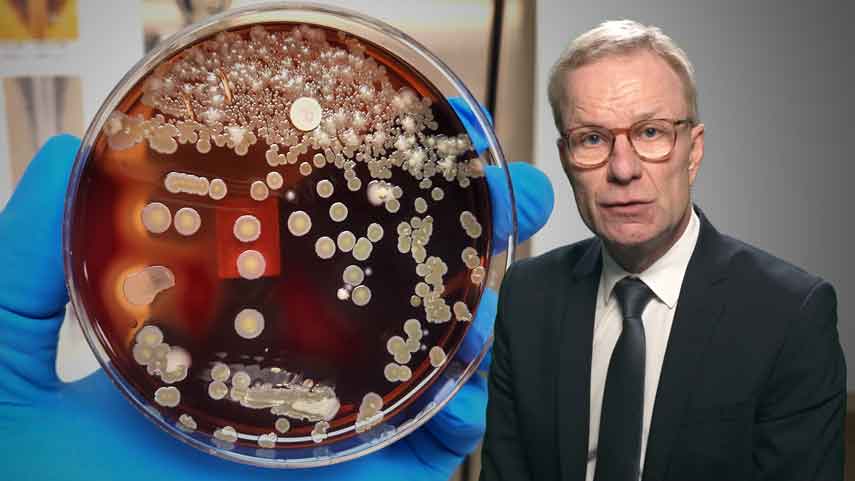
Multiresistene Erreger (MRE)

Unsere infektiologischen CME Fortbildungen unterstützen dich dabei, Infektionskrankheiten sicher zu erkennen, rationell zu behandeln und durch Antibiotic Stewardship sowie Impfberatung zur Resistenzprävention beizutragen.
CME-Kurse für Infektiologen
Diese CME-Inhalte erwarten dich auf Doctorflix
Im Fachbereich Infektiologie erhältst du einen umfassenden Überblick über die Diagnostik und Therapie relevanter Infektionskrankheiten – von häufigen ambulanten bis hin zu komplexen nosokomialen Infektionen.
Ein zentraler Bestandteil ist das rationale Antibiotikum- und Antivikamanagement: Indikationsstellung, Deeskalation und Antibiotic Stewardship zur Resistenzprävention, Therapie bakterieller Infektionen der Atemwege, Harnwege und des ZNS sowie evidenzbasiertes Management von HIV, Hepatitis und opportunistischen Infektionen.
Ein weiterer Schwerpunkt liegt auf Sepsis, Impfprävention und Reisemedizin: Frühdiagnose und Therapie der Sepsis nach aktuellen Leitlinien, aktuelle STIKO-Impfempfehlungen, sexuell übertragbare Infektionen sowie reisemedizinische Prophylaxe und Tropenkrankheiten werden praxisnah vermittelt.
Damit bietet dir dieser Fachbereich eine praxisnahe Grundlage für die kompetente infektiologische Versorgung im klinischen und ambulanten Alltag.